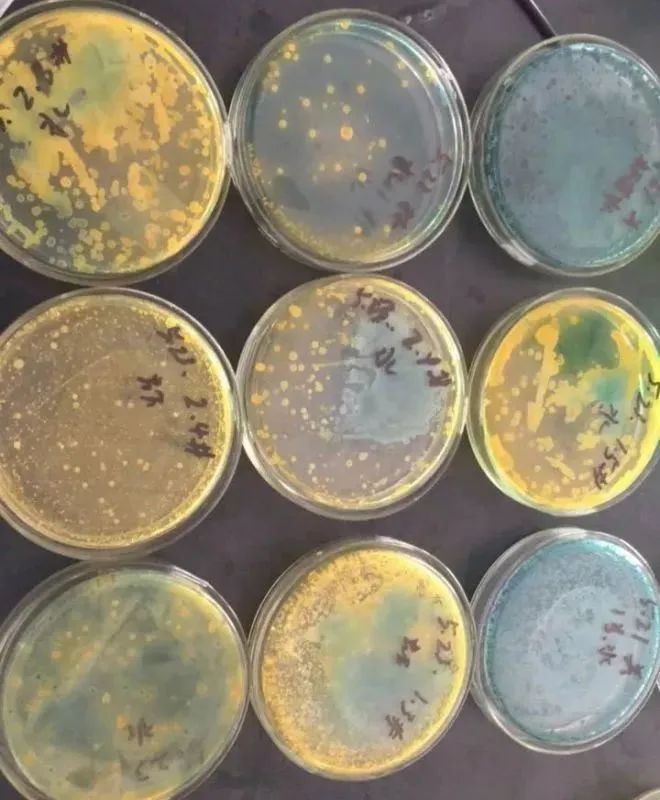
色翁荡息又大又硬又粗又爽

色翁荡息又大又硬又粗又爽-午夜亚洲福利av-在线观看黄网视频免费播放-日本三级吃奶头添泬玉蒲团-欧美精品综合一区二区在线观看
地址:山东省.泰安市.泰前
电 话:0538-8505866
传 真:0538-8505966
财富热线:18660886576
虾苗期弧菌较多可以安全消毒消毒吗?有很多养殖朋友反映,自己的虾塘在放苗进去以后发现池塘中的弧菌含量超
标,想消毒,但是又怕对虾苗刺激较大,不去消毒又怕弧菌爆发造成排塘,该怎么办!
首先告诉大家,苗期是可以消毒的,但是要选对正确的消毒产品,目前来说,市面上常见的消毒剂比如二氧化氯,
强氯精,戊二醛在虾苗期都是不建议大家使用的,首先,这些消毒剂都有很大的刺激作用,当我们把弧菌杀死以
后,虾苗也会因为受到刺激出现应激和掉苗的现象,伤敌一千,自损八百。
一般来说,弧菌是厌氧菌,如果水体溶氧不足,底质“氧债”严重,就会给弧菌滋生提供了有利条件。另外,水
温、饵料与弧菌含量有密切联系,当水温不变时,饵料量的增大,弧菌量就增加;饵料不变时,水温升高则弧菌含
量就增加。
如果亲虾或者是虾苗时期,就感染上了弧菌病,这不仅会直接危害亲虾的生存,而且还会影响亲虾受精卵的发育、
幼体的发育、虾苗的健康。毕竟 ,弧菌不仅能寄生在亲虾的肝脏、血液、肌肉当中,而且还能通过遗传感染至无节
幼体中,具有破坏性大、传染性强、危害深远的特点。
弧菌病虽然严重,弧菌来源虽然难以避免,然而,弧菌并不是难以抑制的,弧菌病更不是绝症,千万不要给弧菌
病,扣上“绝症”的帽子!
我们了解了来源,自然可以很轻松的从源头入手,抑制弧菌的大量繁殖和感染。勤改底,定期改底,保证底质环境
良好。养殖户一定不要认为,改了底就改好了底,也不要认为,勤改底底质就不会出问题,这都是错误的观念。我
们在日常管理中,定期改底的同时,还要注意观察底质、水质情况,如果水质也不好,一昧的改底,那效果必然也
不会很好。
声明:本公众号未注明出处的转载文章是出于传递更多信息之目的。若有未注明出处或标注错误或侵犯了您的合法
权益,请我们联系,我们将及时更正、删除,谢谢!